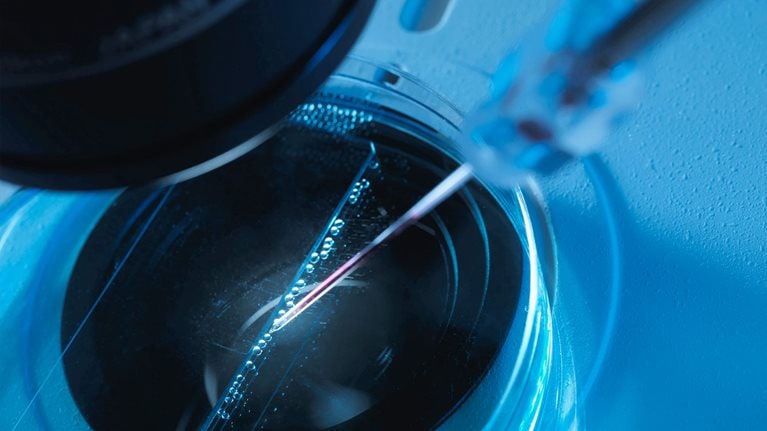

医薬品と医療機器において世界第2位の市場規模を有する日本市場において、中小企業から大手企業まで多くの日本の製薬企業や医療機器メーカー、多国籍のヘルスケア企業からなるクライアント企業の課題解決を支援しています。
中でも、新技術開発やバイオベンチャーの支援を含むイノベーションの促進や、デジタルアナリティクスを活用したオペレーティングモデルの変革など、急速な市場・技術の変化に合わせた支援をバリューチェーン横断で推進しています。クライアント企業の課題解決を通し、ライフサイエンスプラクティスは多くの患者様の体験向上、さらにはソーシャルインパクトの実現を目指しています。